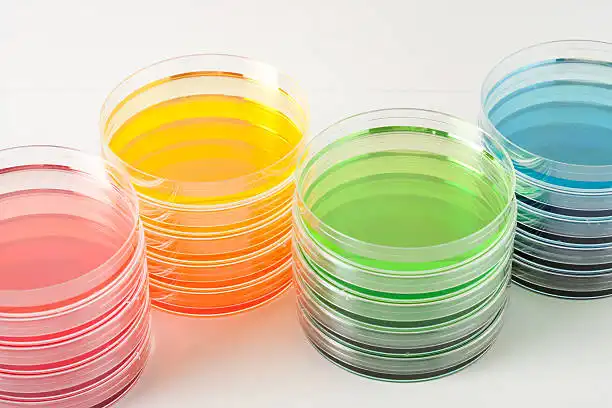
Petri kutuları

Gosselin ürünleri gıda, veteriner, farmasötik ve su mikrobiyolojisi laboratuarlarının kullanımına yönelik tasarlanmıştır. Gosselin Avrupa’ nın lider petri kutusu üreticisidir. Tüm Gosselin ürünleri uluslararası standartlara uygun olarak üretilmektedir ve FDA onaylıdır. Gosselin yine kendi yatırımı olan ELECTRON NORD tesisleri sayesinde beta ışınları ile yüksek doz-kısa süre uygulaması ile paket bazında sterilizasyon imkanına sahiptir.